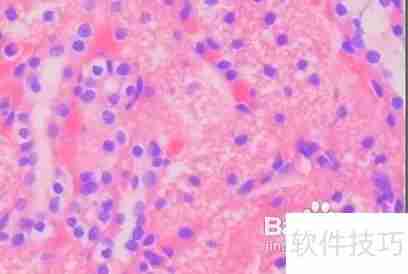
健康体检都包含哪些内容？全面了解体检项目

您的位置:首页 >健康体检项目有哪些?全面解析体检内容
发布于2025-07-24 阅读(0)
扫一扫,手机访问
?
起床后暂时不要排尿。
到接待处依据体检项目缴纳费用,获取个人体检表格并按指示填写个人信息。
接受抽血以检测血常规及各类生化指标。
女性在膀胱充盈时接受B超检查。
留取尿样进行常规检验。
接受内科、外科与五官科的检查,并由医师判断健康情况。
进行胸部X光检查。
测量血压、体温、身高及体重等基础健康数据。
完成心电图测试。
下一篇:无期迷途雷温技能加点推荐
售后无忧
立即购买>office旗舰店
售后无忧
立即购买>office旗舰店
售后无忧
立即购买>office旗舰店
售后无忧
立即购买>office旗舰店
正版软件
正版软件
正版软件
正版软件
正版软件
1
2
3
4
5
6
7
8
9